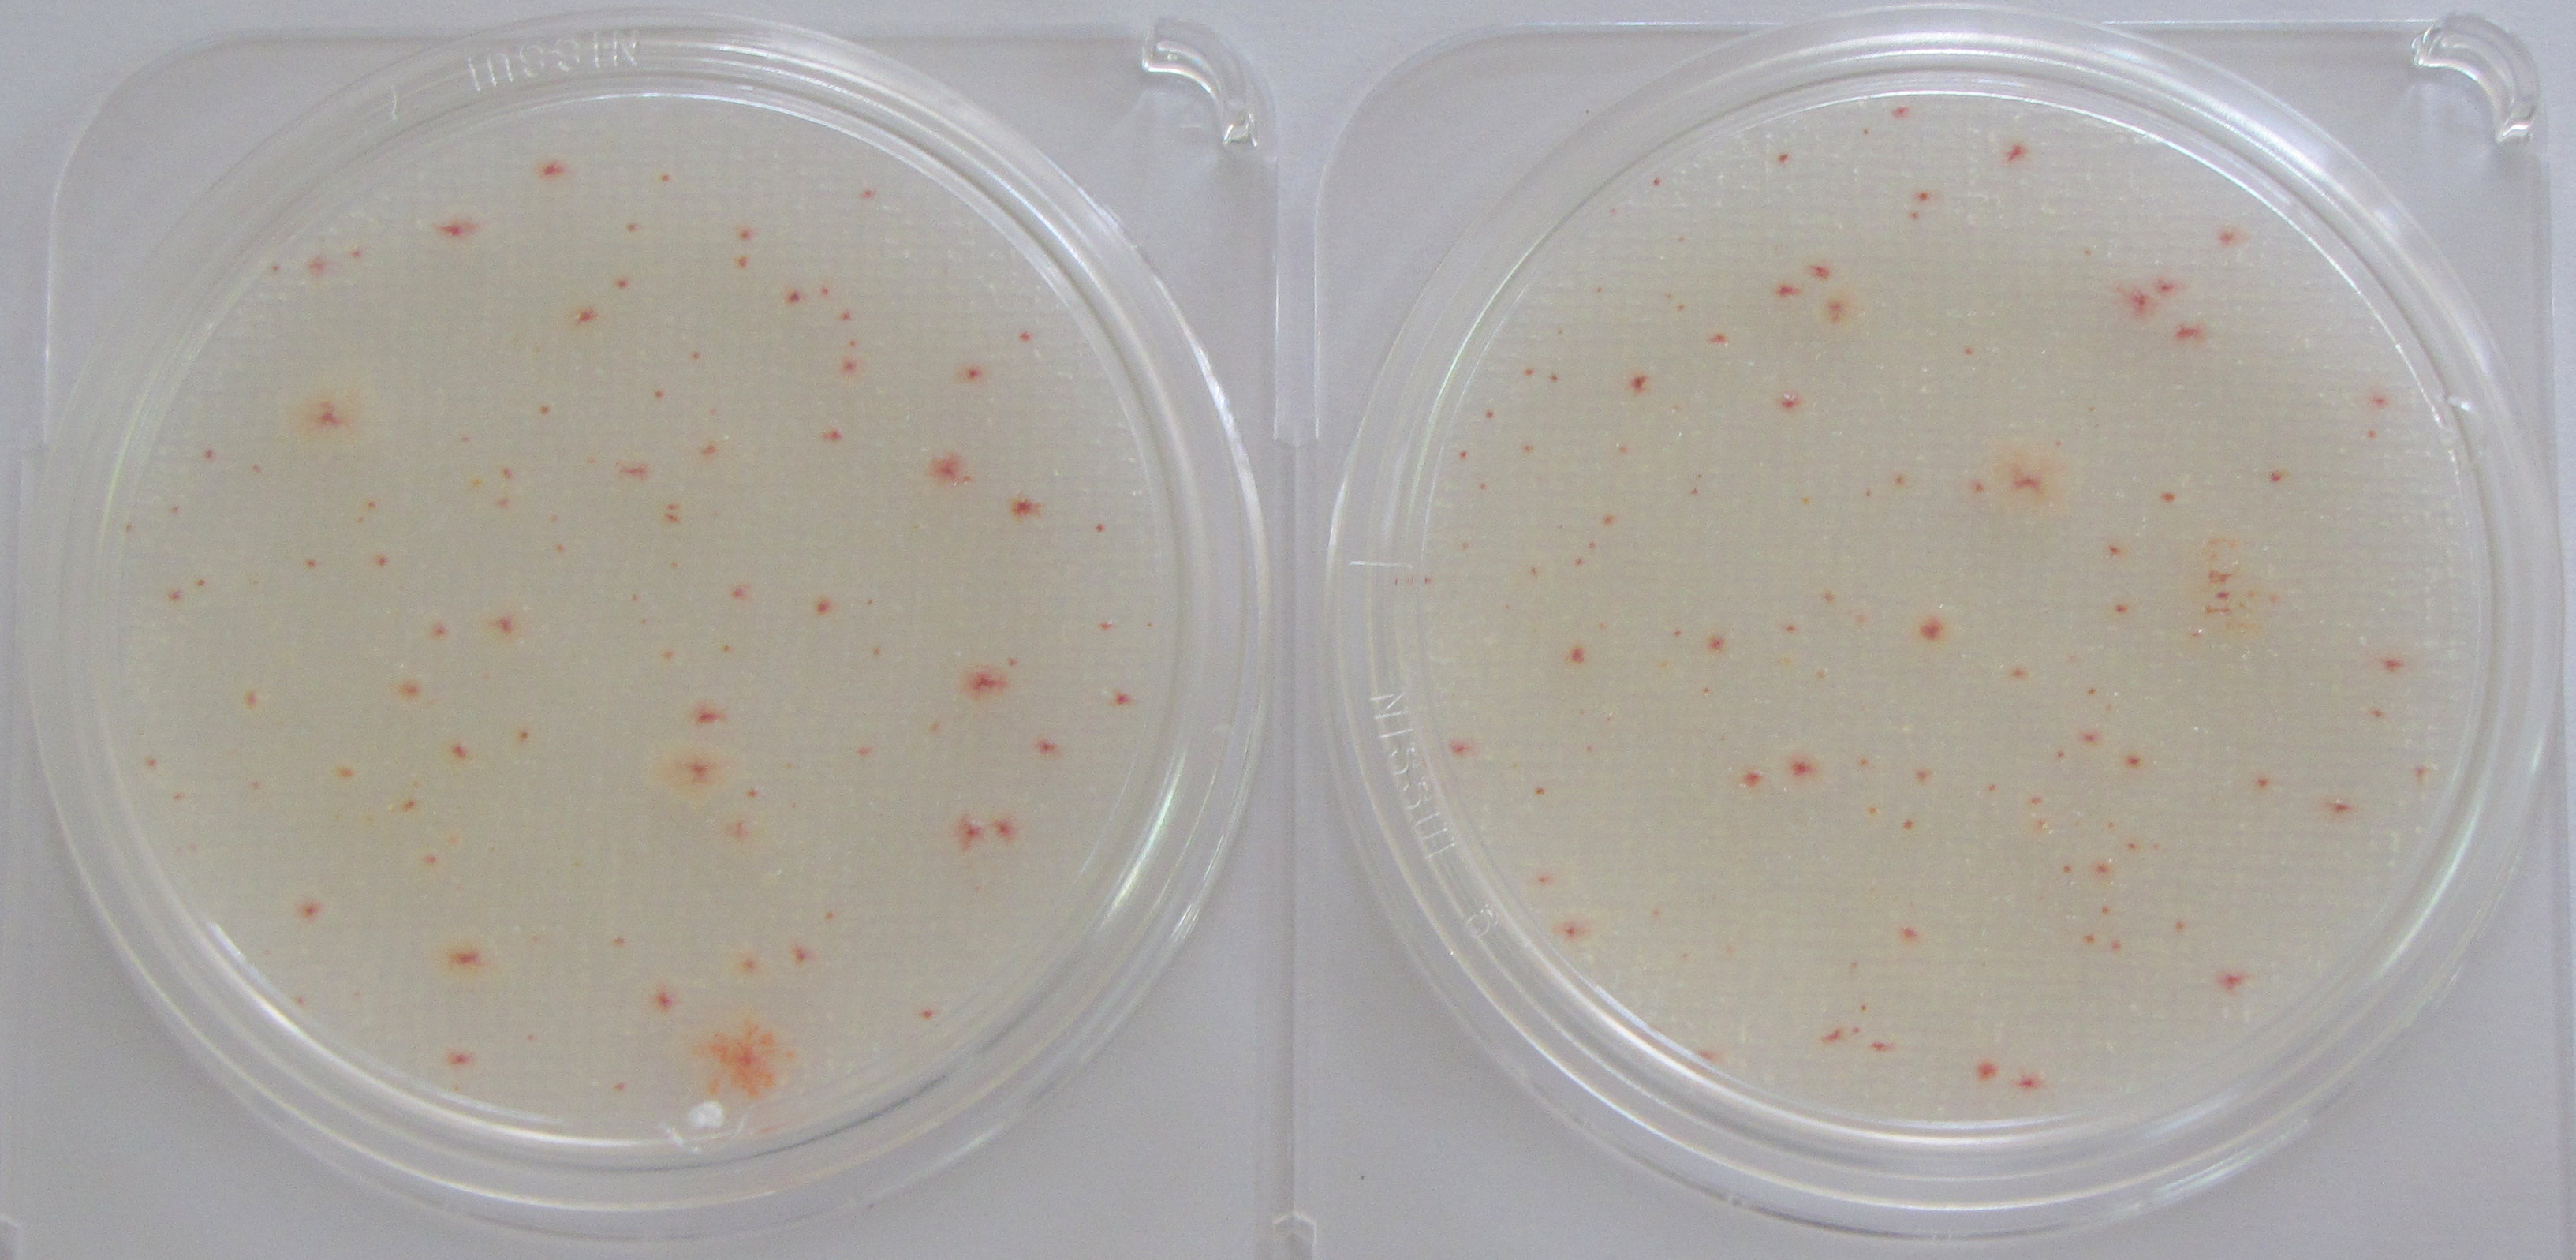
제품사진

빠르고 혁신적인 기술을 가지고 풍요로운 삶을 창조하는
유원엔지니어링을 방문해 주신 여러분을 환영합니다.
◉ 자외선의 살균파장(UV-C•254nm)이 미생물 (바이러스, 세균, 곰팡이, 효모 등)의 DNA를 직접 파괴하여 즉시 불활성화(Disinfection) 및 사멸시킴.

원수(살균기통과전)
원수(살균기통과전)

|
조사량
모델
|
20 mj | 30 mj | 40 mj | 50 mj | 60 mj | 70 mj | 80 mj | 90 mj | 100 mj |
|---|---|---|---|---|---|---|---|---|---|
| S-P6 (T/H) | 900 T | 750 T | 540 T | 450 T | 360 T | 270 T | 240 T | 210 T | 180 T |
| S-P4 (T/H) | 600 T | 500 T | 360 T | 300 T | 240 T | 180 T | 160 T | 140 T | 120 T |
| S- 4 (T/H) | 300 T | 250 T | 180 T | 150 T | 120 T | 90 T | 80 T | 70 T | 60 T |
| S- 1 (T/H) | 50 T | 40 T | 30 T | 25 T | 20 T | 15 T | 13 T | 11 T | 9 T |
| 최소살균 조사량 | 미생물 종류 |
|---|---|
| 20 ~ 30 mj /㎠ | 비브리오, 외피바이러스, 수질지표균, 대장균, 섬모충 등 원생동물, 효모형진균, 곰팡이•조류 등 |
| 40 ~ 60 mj /㎠ | 바실러스, 클로스트리디움 등 포자형 세균 폴리오바이러스 등 RNA 바이러스, DNA 바이러스 |
| 70 ~ 100 mj /㎠ 이상 | 매우 강한 내성을 가진 클로스트리움 세균 포자, 내생 세균 포자(Endospore)완전 불활성화, 멸균 수준 |
| 모 델 | 시간당 처리 용량 (30 ~20 mj) |
IN • OUT | 규격 | 재질 | 전압 • 소비전력 | 비 고 |
|---|---|---|---|---|---|---|
| Y – S 1 | 40~60 T/H | 50A | 150∅ x1,300 |
PP | 220V • 250W | |
| Y – S 4 | 200~300 T/H | 200A 후렌지 |
300∅ x1,300 |
PP | 220V • 1,000W | |
| Y - SP4 | 400~600 T/H | 250A 후렌지 |
660∅ x1,300 |
PP | 220V • 2,000W | |
| Y - SP6 | 700~1,000 T/H | 300A 후렌지 |
770∅ x1,300 |
PP | 220V • 3,000W |



(주)유원 ENG대표 : 윤세성
유원엔지니어링
주소 : 광주 북구 하서로523번길 100
사업자 등록번호 : 410-04-64397
업태/종목 : 도매 및 제조업 종목 환경기계 등
전화 : 062-945-9425 팩스 : 062-945-9426
Call Center대표전화